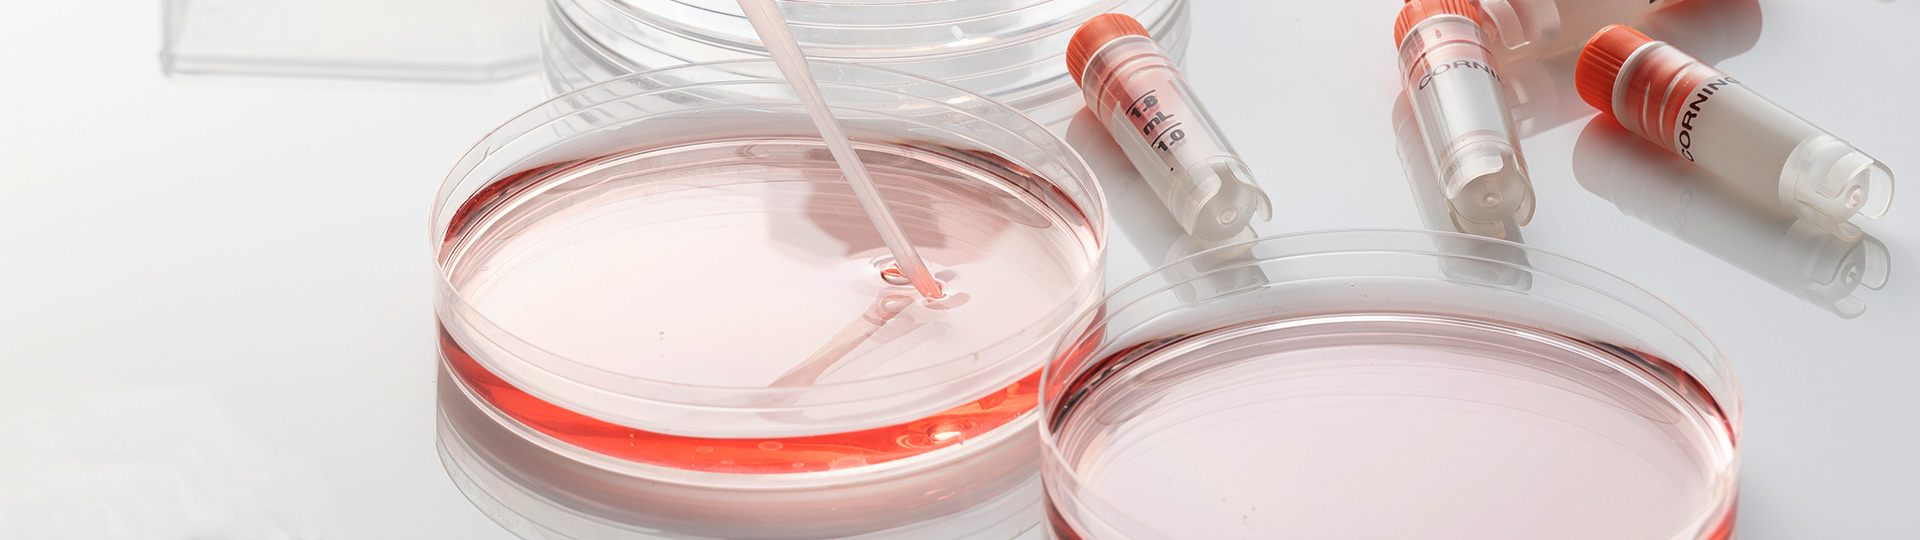

細胞の品質管理
これは、臨床的な新薬の開発、病気の治療、外傷、医学的な臨床研究になどのために使用されている医療ユニットです。 培養の過程では、動物由来の成分が禁じられているため、初代培養から10代目の幹細胞まで、厳格なDAG培養管理ガイドライン(医薬品製造グレード仕様)を実施し、臨床研究機関が求める細胞品質を確保しています。
GCTPの無菌性およびエンドトキシンなどのテストに合格した医薬品グレードの無血清培地(SFM)を使用
-
細胞/組織保存液には動物成分の不使用
-
動物由来のタンパク質を含まないことによる細胞製品の収量と品質の向上
-
無血清栽培を使用したことによる培養の安定性の向上